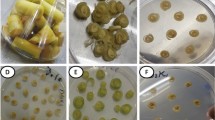

Abstract
Clonal propagation is an important biotechnological tool for the conservation of rare, endangered and threatened as well as commercially important plant species of which orchids are an important representative. In the present research, an attempt was made to develop a fast, clonally stable as well as phytochemically enriched regeneration protocol for propagating Dendrobium aphyllum, an important medicinal orchid using transverse thin cell layer (t-TCL) explants. Murashige and Skoog (MS) medium supplemented with 15 µM meta-topolin along with 10 µM TDZ and 10 µM AgNO3 was found to be most conducive for shoot proliferation. After 8 weeks of culture, an average of 39.41 shoots/explant proliferated; till date this is the best shooting frequency for D. aphyllum and one of the best amongst the orchids. The highest rooting frequency of 82.34% was accomplished in half-strength MS medium supplemented with 15 µM IBA. The plantlets were successfully acclimatized in greenhouse exhibiting normal developmental patterns and flowering occurred after 6 months of acclimatization with 3–4 flowers/stalk irrespective of the flowering season. The genetic homogeneity of the micropropagated plants was ascertained using IRAP and ISSR markers. A comparative assessment of the antioxidant activity (mother and micropropagated plant) was performed using DPPH and FRAP assays which was recorded to be higher amongst the in vitro-regenerated plants. A rapid, genetically stable regeneration protocol coupled with comprehensively higher phytochemical yield is reported in the present study on D. aphyllum. The results of this study confirm the use of in vitro propagation protocol for sustainable commercial utilization as well as conservation of medicinal orchid bio-resources within a limited time period.
Similar content being viewed by others
Avoid common mistakes on your manuscript.
Introduction
Orchids are one of the most diversified groups amongst the flowering plant families and are valued highly for their long-lasting flowers exhibiting an extensive diversity in color, shape, size and fragrance. Amongst the various orchid genera, Dendrobium is one of the most important genera. It is one of the largest in the orchidaceous family comprising 900–2000 species and is the most popular cut flower orchid (Paul et al. 2017; Bhattacharyya et al. 2015a; Baker and Baker 1996). However, due to higher deforestation activity and other anthropogenic pressures, various orchid genera including Dendrobium aphyllum Roxb. are facing risk of habitat destruction (Nayak et al. 1997; Hossain et al. 2012). Apart from having immense horticultural importance, dendrobes also have a significant use in various traditional pharmacopeia (Bulpitt 2005). Primarily, the chemical entities that are found in dendrobes are phenolic compounds, polysaccharides, alkaloids having multiple biological activities including immunomodulatory, antioxidant and anti-tumor effects (Ng et al. 2012; Yang et al. 2015). Chinese pharmacopeia (2010 version) has two monographs of medicinally important dendrobes, of which, one is known as Dendrobii caulis (Shihu in Chinese) constituting D. nobile, D. fimbriatum, D. aphyllum and other related dendrobes and the other one known as Dendrobii officinalis caulis (Tiepi Shihu in Chinese) derived from D. officinale (Yang et al. 2015). Traditionally, the paste of D. aphyllum is used in the treatment of organ deformities (Hossain 2009; Hossain et al. 2012; Yang et al. 2015). This medicinal attribute of D. aphyllum is primarily due to the presence of phytoconstituents such as bibenzyls, phenanthrenes and flavones (Ng et al. 2012; Yang et al. 2015). Apart from its medicinal use, the flowers are also very attractive, having demand in horticulture industry (Hossain et al. 2012). Effective usage of plant tissue culture strategies facilitates an up-regulation of the secondary metabolite-synthesizing activity of the propagated plants including medicinal orchids (Bhattacharyya et al. 2014, 2016). Only a few reports exist on the phytochemical profiling of the micropropagated medicinal orchids (Giri et al. 2012; Bhattacharyya et al. 2014, 2015a, 2016; Bose et al. 2017a, b). Being a highly medicinal orchid, having multi-target drug effects, D. aphyllum is reported to have a high degree of antioxidant activity (Yang et al. 2015). Recent researches have revealed the role played by various antioxidants in reducing the oxidative damage caused by various disorders such as cancer, AIDS and cataracts. This necessitates the development of strategies which would lead to magnify the antioxidant activity within the micropropagated clones through in vitro regeneration pathways.
Keeping in view the immense pharmaco-horticultural importance of D. aphyllum, tissue culture is the best suited approach to supply quality planting materials from both mass propagation and conservation perspectives (Dohling et al. 2012). Although a few reports exist on in vitro propagation of D. aphyllum (Nayak et al. 1997; Talukdar 2001; Hossain et al. 2012), there is a need for a fast, clonally stable and phytochemically superior regeneration protocol facilitating the concept of sustainable conservation (Benson 2002; Nalawade and Tsay 2004). Plant tissue culture has played the most important role in achieving the goal of sustainable conservation. Generally, the plants are either propagated through organogenesis or somatic embryogenesis, but in recent past, thin cell layers (TCL) or thin cross sections (TCSs) of plant tissues such as shoots, stem nodes, protocorm-like bodies (PLBs) have been successfully used for clonal propagation of dendrobes (Bui Van et al. 1999; Zhao et al. 2007). The TCL comprise tissue segments of small size (0.1–5 mm) excised transversally or longitudinally from different plant tissues. It has been used as an effective alternative to the conventional regeneration systems and plant transformation studies and have proved to be a better suited propagule in terms of regeneration frequency including orchids (Bui Van et al. 1999; Rout et al. 2006; Rangsayatorn 2009; Bose et al. 2017b).
Furthermore, to achieve a fast, rapid and stable regeneration protocol, the importance of choosing appropriate plant growth regulator (PGR) complements is essential. Traditionally, the orchids have been propagated using purine-based cytokinins such as 6-benzyl amino purine (BAP) and kinetin (Kn). Recently, topolins have emerged as an effective alternative to conventional cytokinins. Amongst the various forms of topolins, meta-topolin (mT) has proved to be an extremely reliable PGR and has been applied in various plant species including orchids (Vasudevan and Van Staden 2011; Aremu et al. 2012; Bhattacharyya et al. 2016). Coupled with that, in vitro shoot proliferation rate can be further magnified by synergistic use of silver nitrate (AgNO3) which acts as an ethylene suppressor and enhances the rate of shoot proliferation (Cruz de Carvalho et al. 2000; Chithra et al. 2004; Sridevi and Giridhar 2014; Sgamma et al. 2015). However, the sustainability of in vitro propagation techniques principally depends on the production of true-to-type plants so that the advantage in the use of elite genotypes over natural seedlings is maintained (Goel et al. 2009). Several factors such as species type, donor genotypes, explants source and media composition contribute to somaclonal variability (Larkin and Scowcroft 1981; Devi et al. 2014; Bhattacharyya et al. 2014) which might be heritable (Jain 2001). Thus, to ensure clonal fidelity, assessment of genetic stability of the propagated plants is necessary. In recent years, molecular markers such as randomly amplified polymorphic DNA (RAPD), inter-simple sequence repeats (ISSR), simple sequence repeats (SSR) have been successfully applied to evaluate the genetic homogeneity of the regenerated plants. Targeting a particular region of the genome, the conventional molecular marker such as RAPD has a certain limitation which has been greatly improvised by the usage of gene-targeted markers of which inter-retrotransposon-targeted amplified region (IRAP) deserves special mention (Poczai et al. 2013; Bhattacharyya and Van Staden. 2018). IRAP has been proved to be an effective low-cost molecular marker for detecting genetic fidelity with high precision amongst micropropagated plants including orchids (Bhattacharyya et al. 2016).
Although a few propagation protocols have been developed for the propagation of D. aphyllum, there is no report pertaining to TCL-based micropropagation of D. aphyllum along with phytomolecular assessment of the in vitro-raised plantlets. Therefore, the present study was undertaken taking into consideration the following objectives: (1) to develop a high-frequency micropropagation protocol using transverse thin cell layer (t-TCL) culture of nodal segments of this medicinally important orchid species, (2) to assess genetic conformity amongst the regenerates and donor plants using ISSR and IRAP molecular markers, and (3) to evaluate the production of photosynthetic pigments and secondary metabolites in wild and tissue culture-raised plantlets.
Materials and methods
Plant material and explant preparation
Ten-year-old plant of D. aphyllum (Fig. 1a) maintained in the greenhouse of the Plant Biotechnology Laboratory, Department of Botany, North-Eastern Hill University (NEHU), Shillong, India, was used as a donor plant from which nodal segments were excised. The explants were thoroughly washed under flowing tap water for a 30 min time period and were surface sterilized in accordance with the protocol outlined by Dohling et al. (2012). Thereafter, the excised nodal segments were further transversally sliced into thin sections of 0.1–0.4 mm size and used as explants for micropropgation.
In vitro propagation of D. aphyllum from t-TCL explants. a Mature plant growing in green house. b Emergence of adventitious buds at the peripheral region of the t-TCL after 2 weeks of culture (bar = 10 mm). c Closeup view of the initiation of leaf from t-TCL section (bar = 1 cm). d Proliferation of adventitious buds at the basal part of the explant (bar = 1 cm). e Regeneration of the adventitious buds into a tissue clump after 2 weeks in the same media (bar = 1 cm). f Development and proliferation of regenerated multiple shoots in MS + 10 µM + TDZ + 15 µM mT after 2 weeks (bar = 1 cm). g Multiplication of shoots in MS + 15 µM mT and 10 µM TDZ after 8 weeks of culture (bar = 1 cm). h Rooting in half-strength MS + 15 µM IBA after 8 weeks of culture. i Complete plantlets with roots (bar = 1 cm)
Culture medium and growth conditions
To assess the effect of mT on multiple-shoot proliferation, the t-TCL explants were cultured in MS medium (Murashige and Skoog 1962) supplemented with 3% sucrose as carbon source and varying concentrations of mT (High Media, Mumbai, India). Furthermore, to determine the synchronized effect of mT with thidiazuron (TDZ) and α-naphthaleneacetic acid (NAA), the t-TCL explants were cultured in MS medium supplemented with optimum concentration of mT (15 µM) along with varying concentrations of TDZ or NAA (5–20 µM). The pH of the culture medium was adjusted to 5.8 using 0.1N NaOH or HCl before autoclaving. The culture vessels containing the medium were autoclaved at 121 °C for 20 min at 104 kPa pressure. The experiments were repeated three times and each treatment consisted of 10 replicates with each culture period lasting for 8 weeks’ time. The cultures were maintained under ambient culture room conditions [temperature 25 ± 2 °C; relative humidity 80%; light intensity 35–50 µmol/m2/s]. The light illuminance was provided by cool white fluorescent tubes (Philips, Kolkata, India).
Effect of AgNO3 on shoot proliferation
To assess the effect of AgNO3 on the shoot proliferation and multiplication of D. aphyllum, the proliferated shoots obtained as a result of treatments with various PGRs were cultured in MS medium supplemented with varying concentrations of AgNO3 (5–25 µM). Number of proliferated shoots proliferated were recorded both at the time of culture as well as after 4th and 8th weeks of culture initiation. Experimental parameters such as number of replicates and culture conditions were similar as mentioned above.
Effect of auxins on rooting
Proliferating shoots of D. aphyllum with two or three leaves were cultured in half-strength MS medium complemented with 5–20 µM indole butyric acid (IBA) or NAA and maintained under a 12-h photoperiod with an illuminance of 50 µmol/m2/s. The data on total number of roots generated and length were recorded after 4-week time period.
Hardening and acclimatization
The full-grown plants with proliferated roots were carefully removed from the culture bottles. The plants were washed thoroughly to remove any traces of solidifying agar fragments and were then transferred to thermocol pots containing potting mixture [vermiculite and sawdust in 1:1 ratio] along with top layer of moss for moisture retention. This step is outlined as primary hardening. The primary hardened plants were kept at a temperature of 25 ± 2 °C under a 12-h photoperiod (50 µmol/m2/s) for 2 weeks’ time. The plants were sprayed with 1/10th MS medium without sucrose and were then transferred to the growth chamber [(Conviron, Canada); temperature 20 °C; light 50 µmol/m2/s] for secondary hardening. Finally, after successful secondary hardening, the plants were transferred to greenhouse.
Statistical analysis
The recorded experimental data were all subjected to analysis of variance (ANOVA) using SAS software package (SAS-JMP Software Package, USA). The means were compared using Duncan’s multiple range test (Duncan 1955). All the experiments were repeated three times.
Assessment of genetic fidelity using IRAP and ISSR markers
Total genomic DNA was extracted from the young leaves of both mother as well as micropropagated plants D. aphyllum (15 randomly collected plants) using GENEAXY DNA extraction kit (GENEAXY, USA) following the manufacturer’s protocol. The purity of the isolated DNA was checked and quantified using UV spectrophotometer. A total of 35 ISSR and 10 IRAP primers were screened and out of these 9 ISSR and 5 IRAP primers which produced the best amplification and reproducible patterns were selected for the final amplification. ISSR-PCR was carried out in accordance with the methodology described by Bhattacharyya et al. (2015b) whereas IRAP-PCR was carried out following the protocol described by Kalendar and Schulman (2006) with minor modifications. The amplified PCR products were separated using 1.8% denaturating agarose gel electrophoresis with 1X Tris–acetate–EDTA (TAE) tank buffer. The gel profiles were subsequently documented using Biostep DH-20, Gel Documentation System, Germany.
Data analysis
The generated band profiles were scored into a binary matrix on the basis of their presence (1) and absence (0). Only clear and unambiguous bands were taken into consideration whilst the smeared bands were discarded. To assess the robustness and comparative efficacy of the marker systems used to assess genetic stability of the regenerants, various parametric measures such as resolving power (Rp) and polymorphic information content (PIC) for the IRAP and ISSR markers were used (Smith et al. 1997; Prevost and Wilkinson 1999). The binary molecular data obtained from IRAP and ISSR markers were pooled and dendrogram was constructed using NTSYS software package version 2.20K (Rohlf 1998). To determine the robustness of the cladding pattern of the generated dendrogram, the marker data were further subjected to 1000 replicate bootstrap analysis using Free-Tree programme (Pavlicek et al. 1999).
Determination of photosynthetic pigments within the regenerated plants
The level of the photosynthetic pigments present within the mother as well as the micropropagated plants was determined and quantified. Chlorophyll a, b and carotenoids were estimated in accordance with the protocol described by Lichtenthaler (1987) and modified further by Aremu et al. (2012). The photosynthetic pigment contents were expressed in µg/gm FW and calculated in accordance with the formulae outlined below:
Extract preparation and secondary metabolite assessment
The plant parts (leaf and stem) were harvested from both mother as well the micropropagated plants and were cleaned thoroughly under flowing tap water. These were blotted using paper towels and dried at ambient room temperature and were ground into fine powder using REMI mixture grinder (REMI, India). One hundred milligram of this powdered material was weighed and dissolved in 100 ml of different solvents (methanol, chloroform and acetone). All the extractions were carried out using an orbital shaker (REMI, India) adjusted at 170 rpm for a 24-h time period. Finally, the obtained extracts were centrifuged at 10,000 rpm for 10 min and the obtained supernatants were filtered through Whatman filter paper no.1. The obtained plant extracts were assayed for three broad phytochemical parameters, i.e., total phenolic content (TPC), total flavonoid content (TFC) and total alkaloid content (TAC) in accordance with the protocol described by Bhattacharyya et al. (2016). TPC, TFC and TAC were quantified on the basis of gallic acid equivalent (GAE), quercetin equivalent (QE) and atropine equivalent (AE), respectively. The standard curves for the analysis were prepared using absolute methanol (v/v) and the obtained results were expressed in milligram standard equivalent/g of dry weight. The absorbance was recorded using Lambda-35 double spectrophotometer (Perkin-Elmer, USA).
Estimation of antioxidant activity
The antioxidant activities of the mother and the micropropagated D. aphyllum plants were compared using1,1-diphenyl-2-picrylhydrazyl (DPPH) assay according to the method described by Jagtap et al. (2011) and also by ferric reducing antioxidant power (FRAP) assay following the protocol outlined by Benzie and Stain (1996). A correlation coefficient between the TPC, TFC and TAC with the estimated antioxidant activities determined by DPPH and FRAP assays was calculated. The experimental results were expressed as ± SE of three consecutive experiments. Furthermore, the generated data were subjected to ANOVA and the statistical tests of significance between the obtained mean values using Duncan’s multiple range test (Duncan 1955).
Results and discussion
Multiple-shoot induction and proliferation
The efficacy of fast and direct shoot regeneration without an intermediate callus phase using t-TCL explants helped to produce a large number of plantlets of D. aphyllum, widely revered for its immense medicinal and horticultural importance. The t-TCL explants were cultured in MS medium supplemented with various concentrations of mT which showed induction of adventitious buds within 2 weeks of culture (Table 1). Initially, the adventitious buds appeared in the peripheral region of the t-TCL (Fig. 1b, c), but later on emerged from the basal part of the explant (Fig. 1d) and proliferated into a tissue clump (Fig. 1e). Similar reports have been documented in other related plant species including orchids. The number of proliferating shoots/explant was comprehensively higher in comparison to the other reported t-TCL protocols in orchids which substantiates unequivocally the role played by mT in influencing the rate of tissue regeneration pathway-based micropropagation reports in orchids (Bui Van et al. 1999; Nayak et al. 2002; Zhang et al. 2005; Zhao et al. 2007). Amongst the various tested mT concentrations, the highest response with 11.22 shoots/explant was recorded in MS medium supplemented with 15 µM (Table 1). The present shoot initiation rate is significantly higher in comparison to that recorded previously for micropropagation of D. aphyllum (Nayak et al. 1997; Talukdar 2001; Dutta et al. 2011; Hossain et al. 2012). In recent times, mT has evolved as a potential alternative to conventional cytokinins such as BAP and Kn (Werbrouck et al. 1996; Aremu et al. 2012). Due to lesser levels of residual toxicity and higher multiple-shoot-inducing property, it has become a PGR of choice for plant tissue culture experiments. Similar findings were reported in D. nobile and Ansellia africana, two related medicinal orchid species (Vasudevan and Van Staden 2011; Bhattacharyya et al. 2016). The shoot regeneration potentiality was further magnified when the proliferated shoots were cultured further into medium supplemented with varying concentrations of TDZ and NAA along with 15 µM of mT (Table 2; Fig. 1F). Amongst all the treatments, MS medium containing 10 µM of TDZ and 15 µM of mT resulted in the highest rate of shoot proliferation, i.e., 23.22 shoots/explant with an average shoot length of 2.49 cm. The superiority of the TDZ in orchid micropropagation is well documented. It has played an important role in the in vitro propagation of various orchid species including dendrobes (Cheruvathur et al. 2010; Bhattacharyya et al. 2014). The present experimental finding further justifies the potency of TDZ to be used as a PGR of choice in combination with topolins to enhance the pace of in vitro propagation. The conducive effect of TDZ in tissue proliferation is reported to be primarily because of its role in synthesis, accumulation and concentration specific balancing in the ratio of exogenous PGRs which allow specific modes of regeneration (Mok and Mok 1985; Tao et al. 2011). A brief exposure to TDZ ranging from 6–20 days, depending on concentration has been reported to be beneficial for shoot proliferation (Liu et al. 2003; Tao et al. 2011) which is in congruence to our present finding where a significant increment in shoot proliferation was observed when t-TCL explants were further transferred to a medium supplemented with 15 μM mT for a time period of 2 weeks (Table 2; Fig. 1f).
Effect of AgNO3 on multiple-shoot proliferation
When the cultures were maintained in the same medium for prolonged time, there was no significant change in shoot regeneration frequency. To further accelerate the frequency of regeneration along with an increased shoot length, the effect of AgNO3 on the multiple-shoot proliferation of D. aphyllum was tested. Incorporation of AgNO3 in the medium resulted in a significant increment in the number of multiple shoots. Optimum response (35.21 and 39.41 shoots after 4 and 8 weeks of culture) was recorded in MS medium appended with 15 µM mT and 10 µM TDZ along with 10 µM AgNO3 (Table 3; Fig. 1g). This shooting frequency observed in the present report is found to be significantly higher than previously published reports on D. aphyllum (Nayak et al. 1997; Talukdar 2001; Dutta et al. 2011; Hossain et al. 2012). The reason behind getting significantly higher multiplication rate using AgNO3 may be primarily because of the fact that AgNO3 acts as an ethylene inhibitor, a gas which is produced during plant regeneration and inhibits shoot proliferation during clonal propagation (Seong et al. 2005). Addition of Ag2+ ions in the culture medium acts as an antagonist to ethylene biosynthesis and significantly enhances shoot proliferation and multiplication (Kumar et al. 2009). The present study also documents the synergistic effect of mT and TDZ with AgNO3 serving as cell proliferation trigger magnifying the multiple-shoot number significantly. The conducive effect of the Ag2+on the shoot bud multiplication and elongation has been reported earlier by various other coworkers and our research finding is in agreement with their findings (Hyde and Phillips 1996; Brar et al. 1999; Giridhar et al. 2003; Sridevi and Giridhar 2014; Sgamma et al. 2015).
Rooting and acclimatization of plantlets
The proliferated full-grown shoots were transferred to the rooting medium supplemented with either IBA or NAA ranging in concentrations between 5 and 20 µM. However, the percentage of rooting in the full-strength MS medium was found to be not desirable (data not shown); therefore, half-strength MS medium was used. Maximum rooting frequency of 82.34% with 15.22 roots/shoot was recorded in half-strength MS medium containing 15 µM IBA (Table 4; Fig. 1g). Comparatively, IBA is found to be a better auxin in inducing roots over NAA from the recorded parameters such as number of roots/shoot and root length taken into consideration (Table 4; Fig. 1h, e). The efficacy of IBA over other auxins in promoting rooting in orchids is well documented and is in congruence with the findings of other coworkers (Nayak et al. 1997; Cheruvathur et al. 2010). Being an epiphyte, development of well-branched root system is of utmost importance. In the present protocol, the best rooting frequency recorded was 82.34% with an average root length of 5.12 cm and root number of 15.22 roots/shoot which is the best rooting frequency for D. aphyllum reported till date (Table 4). The fully grown plants with developed root systems were transferred to a potting mixture containing vermiculite and saw dust mixture in 1:1 ratio and were maintained in growth chamber under ambient conditions for primary hardening. The micropropagated plants on being transferred to ex vitro conditions are subjected to various abiotic and biotic stresses including temperature variations, which greatly affect the viability of the micropropagated plants (Deb and Imchen 2010). Being epiphytic in nature, acclimatization in dendrobes needs special attention. In nature, as these plants grow in shady environment under low to moderate temperatures, it becomes necessary to create such conditions artificially, referred to as primary hardening (Lavanya et al. 2009; Bhattacharyya et al. 2016). A significant etiolation in the micropropagated shoots of D. aphyllum was observed during the primary hardening process which might be because of the fact that transfer of the plantlets from the in vitro conditions to direct sunlight leads to photoinhibition and chlorophyll bleaching (Van Huylenbroeck. 1995). Coupled with that, abcissic acid (ABA) metabolism also plays a very critical role in the plant growth and development mainly through optimizing plant water balance and regulating the plant response mechanism to various adaptive stress factors including temperature (Hetherington 2001; Finkelstein and Gibson 2002). In the present study, along with the other factors, the use of vermiculite with saw dust in the ratio of 1:1 highly enhanced the hardening efficiency of the micropropagated plantlets. Furthermore, vermiculite played a significant role in the successful acclimatization of the in vitro-raised plantlets. The probable reason behind such an efficacy might be due to the higher moisture retention capacity of the vermiculite and constant absorption of oxygen which can be better availed by the hardened plantlets including dendrobes during the acclimatization process (Paul et al. 2017; Runkles et al. 1958; Zhao et al. 2007). Addition of top layer of moss helped to increase humidity because of its high water retention capacity. The present finding is in close congruence with the findings of Bhattacharyya et al. (2015a) in D. thyrsiflorum. After successful primary hardening, the plants were transferred to greenhouse conditions resulting in about 95% survival rate (Fig. 2a).
a Greenhouse-acclimatized plantlets grown with a potting mixture constituting of vermiculite and saw dust mixture in 1:1 ratio with a top layer of moss. b Development of keikis after 4 months of secondary hardening. c Flowering of the in vitro-raised plants within 6 months of hardening under greenhouse condition
Flowering of the micropropagated plants
The greenhouse-hardened plants of D. aphyllum developed keikis within 4 months of secondary hardening and started flowering after 6 months of secondary hardening (Fig. 2b, c). Initiation and induction of flowers in plants are primarily controlled by various factors such as photoperiod, temperature, irradiance, and water availability (Bernier et al. 1993; Bernier and Périlleux 2005). Coupled with the above physiological conditions, cytokinins also played an important role in induction and maturation of floral buds and might have influenced flowering. The endogenous hormonal level provides an floral stimulus which is then transported through the vascular tissue to the apical meristem and subsequently initiates flower initiation (Bernier and Périlleux 2005). In flowering plant species including orchids, a positive synchrony has been reported with the cytokinin concentration and apical meristem during floral transition phase (Blanchard and Runkle 2008). Along with cytokinins, AgNO3 also plays a significant role in controlling flowering. Being an antagonist of ethylene biosynthesis, Beyer (1976) had reported that higher ethylene concentrations which act as obstacle for floral initiation could be modulated with an optimized use of AgNO3. In our present experimental findings, we have found that micropropagation of the D. aphyllum plants using a synchronized system comprising mT, TDZ along with ethylene suppressor AgNO3 not only enhances the rate of micropropagation but also helps in the induction of an early flowering. Although, Hossain et al. (2012) achieved flowering within the in vitro-propagated plants of D. aphyllum, but the number of the flowers were restricted to 1–2. In this protocol, 3–4 flowers on an average were obtained within 6 months of hardening (Fig. 2c). Furthermore, it justifies the use of mT in the induction of flowering in horticulturally important orchid species like D. aphyllum and is the first report for the induction of in vitro flowering within epiphytic orchids to the best of our knowledge.
Genetic fidelity of the micropropagated plantlets
The occurrence of genetic variability within the micropropagated plants is a major obstacle towards the sustainable commercial utilization of the medicinal plants (Negi and Saxena 2010). Various factors including explant type and PGR stress can contribute to the occurrence of cryptic variations (Goto et al. 1998). While validating the genetic fidelity of the micropropagated plants with that of the mother plant, two marker systems, i.e., IRAP and ISSR have been used. In the final amplification, 5 most reproducible IRAP primers produced 26 amplifiable bands whereas 9 screened ISSR primers generated 50 bands. Both IRAP and ISSR primers produced two polymorphic bands; however, the number of primers used differed in case of two markers (Table 5, S1; Fig. 3a, b). The obtained marker data were pooled together and genetic variability was determined revealing a total of 5.26% clonal variability amongst the regenerants whereas individually IRAP and ISSR markers detected 7.69 and 4% variability amongst the regenerants (Table 5). The Jaccard’s similarity index ranged from 0.93 to 1.00 (Table 5; Fig. 3c, d). Comparative study between IRAP and ISSR primer efficiency revealed that IRAP detected higher variability and proved to be a better marker system in the detection of clonal variability in comparison to ISSR. Being a conventional molecular marker, ISSR targets a specific section of the genome which might not exhibit variability. This limitation has been largely resolved by the usage of retrotransposon-targeted molecular markers, i.e., IRAP (Kilinç et al. 2014). Furthermore, Larkin and Scowcroft (1981) identified the transposable element movement within the genome as an important factor contributing to somaclonal variations within micropropagated plants. Being a retrotransposon-targeted marker, IRAP proved to be a marker of choice for detecting somaclonal variability. As IRAP could amplify genomic distances between two long terminal repeats (LTR), it proved to be more efficient over conventional ISSR marker in the precise detection of clonal variability within the micropropagated plants of D. aphyllum. A comparative study of Rp and PIC values of IRAP and ISSR markers (Tables 5, S1) proved IRAP to be more effective in detection of clonal variability as supported by the findings of Smith et al. (1997), Prevost and Wilkinson (1999) and Kalendar and Schulman (2006). This further advocates the use of multi-marker approach to assess genetic stability within micropropagated plants as a single-marker system cannot detect the entire range of somaclonal variation (Mallón et al. 2010). The present findings reveal, that within the micropropagated plantlets of D. aphyllum, negligible degree of genetic variability exists counter-justifying the suitability of t-TCL as explant source along with the stability of the propagated plants assessed after prolonged micropropagation and acclimatization passage stress. Similar results were reported by Singh et al. (2012) in Eclipta alba, and Chavan et al. (2014) in Ceropegia santapaui, two related medicinal plant species. The above protocol also puts forward the beneficial role of mT in arresting clonal variability and promoting higher growth rate which is in congruence with the findings of other coworkers asserting improvised histogenic stability as well as anti-senescent effects (Werbrouck et al. 1995; Bogaert et al. 2004; Bhattacharyya et al. 2016).
Banding profiles of the acclimatized D. aphyllum plants using a IRAP-LTR-2 primers, b ISSR M [L = 100 bp ladder; lane 1 mother plant (M); lanes 2–16 micropropagated plants of D. aphyllum]; c dendrogram illustrating genetic similarity amongst the mother plant and regenerated plants of D. aphyllum; d cluster analysis of the regenerated plants after 1000-repetition bootstrap analysis
Secondary metabolite and photosynthetic pigment profiling
One of the primary reasons of acclimatization failure within the micropropagated plants is in vitro stress induced during plant tissue culture pathways along with a poorly developed photosynthetic apparatus (Pospisilova et al. 2007). Being an epiphyte in nature, a robust photosynthetic module for orchids is of utmost importance. Thus, to validate the effectiveness of the present micropropagation protocol in the development of photosynthetic capacity of the micropropagated plants, we had quantified the photosynthetic pigment contents within the mother and the micropropagated plants of D. aphyllum. The study revealed higher levels of chlorophyll a, b, total chlorophyll as well as carotenoid levels within the in vitro-raised plants of D. aphyllum in comparison to the mother plant. The leaf extract of the micropropagated plants showed a comprehensive higher yield of carotenoids, chlorophyll a, b and total chlorophyll whereas the stem extracts of the mother plant resulted in the lowest pigment yields (Table 6). The probable reason behind such finding may be justified by the broad-spectrum activity of cytokinins by promoting the formation of photosynthetic pigments as well as the chloroplast proteins (Aremu et al. 2012). Coupled with the conducive effect of the cytokinins, AgNO3 also played a triggering role in upregulating the photosynthetic pigment synthesis (Giridhar et al. 2003). The synchronized effect of cytokinin–AgNO3 significantly resulted in an exponential increase in the photosynthetic pigments within the micropropagated plantlets and thereby resulted in an increased rate of survivability. This finding is in close analogy with that of Amoo et al. (2014).
Along with the positive compliance found in the yield of photosynthetic pigments, a comparative assessment of various secondary metabolite contents between the mother and micropropagated plants of D. aphyllum recorded a significant alteration in the TPC, TFC and TAC levels. Methanolic extracts of the micropropagated plants exhibited higher levels of TPC (49.47 mg GAE/g DW), TFC (8.41 mg QE/g DW) and TAC (57.17 mg/AE/g DW) whereas the lowest values were obtained in the chloroform fractions of the mother plant (Table 7). The highest values of TPC and TFC were recorded within the methanolic stem and leaf extracts respectively of the micropropropagated D. aphyllum plants whereas TAC was noted to be highest within the methanolic leaf extracts of the in vitro raised plants. Various literature studies suggested that D. aphyllum is an important biological reserve for precious therapeutic molecules having a broad-spectrum of usage in traditional Chinese pharmacopeia (Hossain 2011; Yang et al. 2015). The secondary metabolites are important biomolecules having an important role in regulating vital cell functions and regulation of important physiological functions. A wide number of such biomolecules also represent potent therapeutic attributes in combatting cardiovascular disorders and cancer (Palacio et al. 2008; Moyo et al. 2010; Yang et al. 2015). Amongst all secondary metabolites, the presence of alkaloids is the most pronounced within orchids (Bose et al. 2017a, b; Hossain 2011). Coupled with that, the phytochemical profiling of the micropropagated plants obtained by the present cytokinin–AgNO3-mediated regeneration system documents a higher yield of secondary metabolites in comparison to other conventional approaches. The probable reason behind such result might be the positive synchrony between the mT and AgNO3 resulting in an enhanced level of secondary metabollite. Cytokinins such as mT and TDZ are known for their positive effects in enhancing the yield of secondary metabolites within micropropagated orchids which was further pronounced by the addition of AgNO3. Furthermore, the present experimental findings are also closely supported by our previous findings in D. nobile, a related orchid species used in traditional Chinese medicine (TCM) (Bhattacharyya et al. 2016).
Antioxidant activity
The primary reason of a plant to be categorized as medicinal is being estimated by its antioxidant potentials. The antioxidant potential of a medicinal herb develops from the presence of various secondary metabolites of which polyphenols form an important class of biomolecules (Brewer 2011). Having exhibited powerful antioxidant activity in different in vitro cellular models, they have shown potentiality in downregulation of various reactive oxygen species such as hypochlorous acid, superoxide anion, peroxylnitrile, peroxyl and hydroxyl radical (Halliwell 2008). Besides that, recorded antioxidant potential serves as an important benchmark character for the assessment of medicinal activity of the in vitro-propagated plants (Amoo et al. 2012). In the present study, the comparative assessment of antioxidant activity of various plant parts of D. aphyllum (mother and micropropagated) was estimated using DPPH and FRAP antioxidant assays using plant extracts. The highest antioxidant activity was exhibited by the methanolic leaf extract of the micropropagated plants whereas the lowest activity was recorded within the chloroform extracts (Fig. 4a, b). The findings reveal a significant increase in antioxidant activity within the micropropagated plants in comparison to the mother plant which is in congruence with the published reports in medicinal plant species including orchids (Chavan et al. 2014; Bhattacharyya et al. 2015a, 2016). The present report is a preliminary baseline finding which depicts the positive analogy of mT–TDZ–AgNO3 complement in increasing the antioxidant potential within the micropropagated plant which justifies the findings of Amoo et al. (2012). Both DPPH and FRAP methods detected higher degree of antioxidant activity within the leaf extracts of the micropropagated D. aphyllum plants which might be due to the presence of various photosynthetic pigments. Furthermore, when the various secondary metabolite parameters as well as the recorded antioxidant activities were correlated, TPC and TAC showed positive correlation with antioxidant activity whereas TFC did not influence the antioxidant activity significantly (Table S2).
Conclusions
The present research focuses on the development of a t-TCL micropropagation protocol for sustainable exploitation of D. aphyllum, an important medicinal orchid taxon. A significant shoot proliferation rate has been achieved using synergistic effects of mT, TDZ and AgNO3, which is the highest till date in D. aphyllum. The report also comprehensively documents the effect of mT and AgNO3 on dendrobium micropropagation using D. aphyllum as a model plant. A comparative asessment of phytomolecular parameters revealed eliteness of the micropropagated clones in comparison to the donor plants. In precise, the research ascertains high genetic stability and phytochemical enrichment of the clones which makes this protocol ideally suitable for mass propagation. The approach is fast and simple and can be adopted for the production of large volumes of orchid materials for commercial exploitation and conservation, thereby upholding the principle of sustainable commercial exploitation.
Author contribution statement
PB, PP, PT and SK designed the experiments. PB and PP executed the experiments, recorded and analyzed the data. PB and SK wrote and edited the MS.
References
Amoo SO, Staden J, Van (2012) Influence of plant growth regulators on shoot proliferation and secondary metabolite production in micropropagated Huernia hystrix. Plant Cell Tissue Organ Cult 112:249–256
Amoo SO, Aremu AO, Moyo M, Szu¨cˇova´ L, Dolezˇal K, Van Staden J (2014) Physiological effects of a novel aromatic cytokinin analogue in micropropagated Aloe arborescens and Harpagophytum procumbens. Plant Cell Tissue Organ Cult 116:17–26
Aremu AO, Bairu MW, Szüčová L, Doležal K, Finnie JF, Van Staden J (2012) Assessment of the role of meta-topolins on in vitro produced phenolics and acclimatization competence of micropropagated “Williams” banana. Acta Physiol Plant 34:2265–2273
Baker M, Baker M (1996) Dendrobium species culture. Timber Press, Portland. https://www.cabdirect.org/cabdirect/abstract/19970306723
Benson E (2002) Plant conservation biotechnology. CRC Press, Boca Raton
Benzie IFF, Strain JJ (1996) The ferric reducing ability of plasma (FRAP) as a measure of “antioxidant power”: the FRAP assay. Anal Biochem 239:70–76
Bernier G, Périlleux C (2005) A physiological overview of the genetics of flowering time control. Plant Biotechnol J 3:3–16
Bernier G, Havelange A, Houssa C, Petitjean A, Lejeune P (1993) Physiological signals that induce flowering. Plant Cell 5:1147
Beyer EM (1976) A potent inhibitor of ethylene action in plants. Plant Physiol 58:268–271
Bhattacharyya P, van Staden J (2018) Molecular insights into genetic diversity and population dynamics of five medicinal Eulophia species: a threatened orchid taxa of Africa. Physiol Mol Biol Plants. https://doi.org/10.1007/s12298-018-0523-6
Bhattacharyya P, Kumaria S, Diengdoh R, Tandon P (2014) Genetic stability and phytochemical analysis of the in vitro regenerated plants of Dendrobium nobile Lindl., an endangered medicinal orchid. Meta Gene 2:489–504
Bhattacharyya P, Kumaria S, Job N, Tandon P (2015a) Phyto-molecular profiling and assessment of antioxidant activity within micropropagated plants of Dendrobium thyrsiflorum: a threatened, medicinal orchid. Plant Cell Tissue Organ Cult 122:535–550
Bhattacharyya P, Kumaria S, Tandon P (2015b) Applicability of ISSR and DAMD markers for phyto-molecular characterization and association with some important biochemical traits of Dendrobium nobile, an endangered medicinal orchid. Phytochemistry 117:306–316
Bhattacharyya P, Kumaria S, Tandon P (2016) High frequency regeneration protocol for Dendrobium nobile: a model tissue culture approach for propagation of medicinally important orchid species. S Afr J Bot 104:232–243
Blanchard MG, Runkle ES (2008) Benzyladenine promotes flowering in Doritaenopsis and Phalaenopsis orchids. J Plant Growth Regul 27:141–150
Bogaert I, Van Cauter S, Werbrouck SPO, Dolezal K (2004) New aromatic cytokinins can make the difference. In: V International Symposium on in vitro culture and horticultural breeding 725. pp 265–270
Bose B, Choudhury H, Tandon P, Kumaria S (2017a) Studies on secondary metabolite profiling, anti-inflammatory potential, in vitro photoprotective and skin-aging related enzyme inhibitory activities of Malaxis acuminata, a threatened orchid of nutraceutical importance. J Photochem Photobiol B Biol. https://doi.org/10.1016/j.jphotobiol.2017.07.010
Bose B, Kumaria S, Choudhury H, Tandon P (2017b) Insights into nuclear DNA content, hydrogen peroxide and antioxidative enzyme activities during transverse thin cell layer organogenesis and ex vitro acclimatization of Malaxis wallichii, a threatened medicinal orchid. Physiol Mol Biol Plants. https://doi.org/10.1007/s12298-017-0474-3
Brar MS, Moore MJ, Al-khayri JM, Morelock TE, Anderson EJ (1999) Ethylene inhibitors promote in vitro regeneration of cowpea (Vigna unguiculata L.). In Vitro Cell Dev Biol Plant 35:222–225
Brewer MS (2011) Natural antioxidants: sources, compounds, mechanisms of action, and potential applications. Compr Rev Food Sci Food Saf 10:221–247
Bui Van L, Phuong NTH, Hong LTA, Tran Thanh Van K (1999) High frequency shoot regeneration from Rhynchostylis gigantea (orchidaceae) using thin cell layers. Plant Growth Regul 28:179–185
Bulpitt CJ (2005) The uses and misuses of orchids in medicine. QJM 98:625–631
Chavan JJ, Gaikwad NB, Umdale SD, Kshirsagar PR, Bhat KV, Yadav SR (2014) Efficiency of direct and indirect shoot organogenesis, molecular profiling, secondary metabolite production and antioxidant activity of micropropagated Ceropegia santapaui. Plant Growth Regul 72:1–15
Cheruvathur MK, Abraham J, Mani B, Thomas TD (2010) Adventitious shoot induction from cultured internodal explants of Malaxis acuminata D. Don, a valuable terrestrial medicinal orchid. Plant Cell Tissue Organ Cult 101:163–170
Chithra M, Martin KP, Sunandakumari C, Madhusoodanan PV (2004) Silver nitrate induced rooting and flowering in vitro on rare rheophytic woody medicinal plant, Rotula aquatica Lour. Indian J Biotechnol 3:418–421
Cruz de Carvalho MH, Van Le B, Zuily-Fodil Y, Thi AP, Thanh Van KT (2000) Efficient whole plant regeneration of common bean (Phaseolus vulgaris L.) using thin-cell-layer culture and silver nitrate. Plant Sci 159:223–232
Deb CR, Imchen T, 2010. An Efficient In vitro hardening technique of tissue culture raised plants. Biotechnology 9, 79–83
Devi SP, Kumaria S, Rao SR, Tandon P (2014) Single primer amplification reaction (SPAR) methods reveal subsequent increase in genetic variations in micropropagated plants of Nepenthes khasiana Hook. f. maintained for three consecutive regenerations. Gene 538:23–29
Dohling S, Kumaria S, Tandon P (2012) Multiple shoot induction from axillary bud cultures of the medicinal orchid, Dendrobium longicornu. AoB Plants 2012:1–7. https://doi.org/10.1093/aobpla/pls032
Duncan DB (1955) Multiple range and multiple F tests. Biometrics 11:1–42
Dutta S, Chowdhury A, Bhattacharjee B, Natha PK, Dutta BK (2011) In vitro multiplication and protocorm development of Dendrobium aphyllum (Roxb.) CEC Fisher. Assam Univ J Sci Technol 7:57–62
Finkelstein RR, Gibson SI (2002) ABA and sugar interactions regulating development: cross-talk or voices in a crowd? Curr Opin Plant Biol 5:26–32
Giri L, Jugran A, Rawat S, Dhyani P, Andola H, Bhat ID, Rawal RS, Dhar U (2012) In vitro propagation, genetic and phytochemical assessment of Habenaria edgeworthii: an important Astavarga plant. Acta Physiol Plant 34:869–875
Giridhar P, Indu EP, Vijaya Ramu D, Ravishankar GA (2003) Effect of silver nitrate on in vitro shoot growth of Coffee. Trop Sci 43:144–146
Goel MK, Kukreja AK, Bisht NS (2009) In vitro manipulations in St. John’s wort (Hypericum perforatum L.) for incessant and scale up micropropagation using adventitious roots in liquid medium and assessment of clonal fidelity using RAPD analysis. Plant Cell Tissue Organ Cult 96:1–9
Goto S, Thakur RC, Ishii K (1998) Determination of genetic stability in long-term micropropagated shoots of Pinus thunbergii Parl. using RAPD markers. Plant Cell Rep 18:193–197
Halliwell B (2008) Are polyphenols antioxidants or pro-oxidants? What do we learn from cell culture and in vivo studies? Arch Biochem Biophys 476:107–112
Hetherington AM (2001) Guard cell signaling. Cell 107:711–714
Hossain MM (2009) Traditional therapeutic uses of some indigenous orchids of Bangladesh. Med Arom Plant Sci Biotechnol 3:100–106
Hossain MM (2011) Therapeutic orchids: traditional uses and recent advances—an overview. Fitoterapia 82:102–140
Hossain MM, Sharma M, Pathak P (2012) In vitro propagation of Dendrobium aphyllum (Orchidaceae)—seed germination to flowering. J Plant Biochem Biotechnol 22:157–167
Hyde CL, Phillips GC (1996) Silver nitrate promotes shoot development and plant regeneration of chile pepper (Capsicum annuum L.) via organogenesis. In Vitro CellDev Biol Plant 32:72–80
Jagtap UB, Waghmare SR, Lokhande VH, Suprasanna P, Bapat VA (2011) Preparation and evaluation of antioxidant capacity of Jackfruit (Artocarpus heterophyllus Lam.) wine and its protective role against radiation induced DNA damage. Ind Crops Prod 34:1595–1601
Jain SM (2001) Tissue culture-derived variation in crop improvement. Euphytica 118:153–166
Kalendar R, Schulman AH (2006) IRAP and REMAP for retrotransposon-based genotyping and fingerprinting. Nat Protoc 1:2478–2484
Kilinç FM, Süzerer V, Çiftçi Y, Onay A, Yıldırım H, Uncuog˘lu AA, Tilkat E, Metin OK, Ibrahim K, Akdemir OF (2015) Clonal micropropagation of Pistacia lentiscus L. and assessment of genetic stability using IRAP markers. Plant Growth Regul 75:75–88
Kumar V, Parvatam G, Ravishankar GA (2009) AgNO3: a potential regulator of ethylene activity and plant growth modulator. Electron J Biotechnol 12:1–15
Larkin PJ, Scowcroft WR (1981) Somaclonal variation—a novel source of variability from cell cultures for plant improvement. Theor Appl Genet 60:197–214
Lavanya M, Venkateshwarlu B, Devi BP (2009) Acclimatization of neem microshoots adaptable to semi-sterile conditions. Indian J Biotechnol 8:218–222
Lichtenthaler HK (1987) Chlorophylls and carotenoids: pigments of photosynthetic biomembranes. Methods Enzym 148:350–382
Liu CZ, Murch SJ, El-Demerdash M, Saxena PK (2003) Regeneration of the Egyptian medicinal plant Artemisia judaica L. Plant Cell Rep 21:525–530
Mallón R, Rodríguez-Oubiña J, González ML (2010) In vitro propagation of the endangered plant Centaurea ultreiae: assessment of genetic stability by cytological studies, flow cytometry and RAPD analysis. Plant Cell Tissue Organ Cult 101:31–39
Mok MC, Mok DWS (1985) The metabolism of [14C]-tMdiaziiroii in callus tissues of Phaseolus lunatus. Physiol Plant 65:427–432
Moyo M, Ndhlala AR, Finnie JF, Van Staden J (2010) Phenolic composition, antioxidant and acetylcholinesterase inhibitory activities of Sclerocarya birrea and Harpephyllum caffrum (Anacardiaceae) extracts. Food Chem 123:69–76
Murashige T, Skoog F (1962) A revised medium for rapid growth and bio assays with tobacco tissue cultures. Physiol Plant 15:473–497
Nalawade SM, Tsay H-S (2004) In vitro propagation of some important Chinese medicinal plants and their sustainable usage. In Vitro CellDev Biol—Plant 40:143–154
Nayak NR, Rath SP, Patnaik S (1997) In vitro propagation of three epiphytic orchids, Cymbidium aloifolium (L.) Sw., Dendrobium aphyllum (Roxb.) Fisch. and Dendrobium moschatum (Buch-Ham) Sw. through thidiazuron-induced high frequency shoot proliferation. Sci Hortic (Amsterdam) 71:243–250
Nayak NR, Sahoo S, Patnaik S, Rath SP (2002) Establishment of thin cross section (TCS) culture method for rapid micropropagation of Cymbidium aloifolium (L.) Sw. and Dendrobium nobile Lindl (Orchidaceae) Sci Hortic (Amsterdam) 94:107–116
Negi D, Saxena S (2010) Ascertaining clonal fidelity of tissue culture raised plants of Bambusa balcooa Roxb. using inter simple sequence repeat markers. New For 40:1–8
Ng TB, Liu J, Wong JH, Ye X, Sze SCW, Tong W, Zhang KY (2012) Review of research on Dendrobium, a prized folk medicine. Appl Microbiol Biotechnol 93:1795–1803
Palacio L, Baeza MC, Cantero JJ, Cusidó R, Goleniowski ME (2008) In vitro propagation of “jarilla”(Larrea divaricata CAV.) and secondary metabolite production. Biol Pharm Bull 31:2321
Paul P, Joshi M, Gurjar D et al (2017) In vitro organogenesis and estimation of β-sitosterol in Dendrobium fimbriatum Hook.: an orchid of biopharmaceutical importance. South African J Bot 113:248–252
Pavlicek A, Hrda S, Flegr J (1999) Free-Tree–freeware program for construction of phylogenetic trees on the basis of distance data and bootstrap/jackknife analysis of the tree robustness. Application in the RAPD analysis of genus Frenkelia. Folia Biol (Praha) 97–99
Poczai P, Varga I, Laos M, Cseh A, Bell N, Valkonen JPT, Hyvönen J (2013) Advances in plant gene-targeted and functional markers: a review. Plant Methods. https://doi.org/10.1186/1746-4811-9-6
Pospisilova J, Synková H, Haisel D, Semoradova S (2007) Acclimation of plantlets to ex vitro conditions: effects of air humidity, irradiance, CO2 concentration and abscisic acid (a Review). Acta Hortic 748:29
Prevost A, Wilkinson MJ (1999) A new system of comparing PCR primers applied to ISSR fingerprinting of potato cultivars. Theor Appl Genet 98:107–112
Rangsayatorn N (2009) Micropropagation of Dendrobium draconis Rchb. f. from thin cross-section culture. Sci Hortic (Amsterdam) 122:662–665
Rohlf FJ (1998) NTSYS-pc version 2.0
Rout GR, Mohapatra A, Jain SM (2006) Tissue culture of ornamental pot plant: A critical review on present scenario and future prospects. Biotechnol Adv 24:531–560
Runkles JR, Scott AD, Nakayama FS (1958) Oxygen sorption by moist soils and vermiculite. Soil Sci Soc Am J 22:15–18
Seong ES, Song KJ, Jegal S, Yu CY, Chung IM (2005) Silver nitrate and aminoethoxyvinylglycine affect Agrobacterium-mediated apple transformation. Plant Growth Regul 45:75–82
Sgamma T, Thomas B, Muleo R (2015) Ethylene inhibitor silver nitrate enhances regeneration and genetic transformation of Prunus avium (L.) cv Stella. Plant Cell Tissue Organ Cult 120:79–88
Singh SK, Rai MK, Sahoo L (2012) An improved and efficient micropropagation of Eclipta alba through transverse thin cell layer culture and assessment of clonal fidelity using RAPD analysis. Ind Crops Prod 37:328–333
Smith JSC, Chin ECL, Shu H, Smith OS, Wall SJ, Senior ML, Mitchell SE, Kresovich S, Ziegle J (1997) An evaluation of the utility of SSR loci as molecular markers in maize (Zea mays L.): comparisons with data from RFLPs and pedigree. Theor Appl Genet 95:163–173
Sridevi V, Giridhar P (2014) In vitro shoot growth, direct organogenesis and somatic embryogenesis promoted by silver nitrate in Coffea dewevrei. J Plant Biochem Biotechnol 23:112–118
Talukdar A (2001) Multiple shoot induction in Dendrobium aphyllum Roxb. J Orchid Soc India 15:35–38
Tao J, Yu L, Kong F, Zhao D (2011) Effect of plant growth regulators on in vitro propagation of Cymbidium faberi Rolfe. Afr J Biotechnol 10:15639–15646
Van Huylenbroeck JM, Huygens H, Debergh PC (1995) Photoinhibition during acclimatization of micropropagated Spathiphyllum “Petite” plantlets. In Vitro CellDev Biol Plant 31:160–164
Vasudevan R, Van Staden J (2011) Cytokinin and explant types influence in vitro plant regeneration of Leopard Orchid (Ansellia africana Lindl.). Plant Cell Tissue Organ Cult 107:123–129
Werbrouck SPO, van der Jeugt B, Dewitte W, Prinsen E, Van Onckelen HA, Debergh PC (1995) The metabolism of benzyladenine in Spathiphyllum floribundum “Schott Petite”in relation to acclimatisation problems. Plant Cell Rep 14:662–665
Werbrouck SPO, Strnad M, Van Onckelen HA, Debergh PC (1996) Meta-topolin, an alternative to benzyladenine in tissue culture? Physiol Plant 98:291–297
Yang D, Liu L-Y, Cheng Z-Q, Xu FQ, Fan WW, Zi CT, Dong FW, Zhou J, Ding ZT, Hu JM (2015) Five new phenolic compounds from Dendrobium aphyllum. Fitoterapia 100:11–18
Zhang Y, But PP, Wang Z-T, Shaw P (2005) Current approaches for the authentication of medicinal Dendrobium species and its products. Plant Genet Resour Charact Util 3:144–148
Zhao P, Wang W, Feng F-S, Wu F, Yang ZQ, Wang WJ (2007) High-frequency shoot regeneration through transverse thin cell layer culture in Dendrobium candidum Wall Ex Lindl. Plant Cell Tissue Organ Cult 90:113–131
Acknowledgements
These authors sincerely thank the funding agencies, Department of Biotechnology (DBT), Government of India and Center for Advanced Studies (CAS) grant from University Grants Commission (UGC), New Delhi.
Author information
Authors and Affiliations
Corresponding author
Additional information
Communicated by M. Capuana.
Electronic supplementary material
Below is the link to the electronic supplementary material.
Rights and permissions
About this article
Cite this article
Bhattacharyya, P., Paul, P., Kumaria, S. et al. Transverse thin cell layer (t-TCL)-mediated improvised micropropagation protocol for endangered medicinal orchid Dendrobium aphyllum Roxb: an integrated phytomolecular approach. Acta Physiol Plant 40, 137 (2018). https://doi.org/10.1007/s11738-018-2703-y
Received:
Revised:
Accepted:
Published:
DOI: https://doi.org/10.1007/s11738-018-2703-y